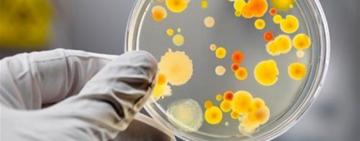
Небезпечний

В Одесі врятували червонокнижного хижого птаха
Екологія
17 липня 2022
В ніч з 16 на 17 липня поряд з одним із будинків на вулиці Володимира Терещенка у...

50 мітингів у 47 містах: у світі стартувала кампанія #terroRussia на підтримку України
Світ
17 липня 2022
У світі стартувала кампанія під назвами #terroRussia та #russiaIsATerrorisState, ціллю якої є визнання рф державою-терористом.
Пр�...

НА ОДЕЩИНІ ПРИКОРДОННИКИ ЗАТРИМАЛИ МІКРОАВТОБУС З ТРЬОМА ТОННАМИ СПИРТУ
Білгород-Дністровський
17 липня 2022
У результаті реалізації оперативної інформації, поблизу населеного пункту Я�...

Кримський міст чекає доля "вишок Бойка" - Арестович
Україна
17 липня 2022
Кримський міст першою частиною проходить територіальними водами України, уточнив А�...

Без відключень світла: ДТЕК Одеські електромережі розпочинає проводити ремонтні роботи під напругою
Одеська область
17 липня 2022
Енергетики ДТЕК Одеські електромережі розпочали проводити ремонтні роботи роз�...

ОПЗЖ та ще кілька партій оскаржують свою заборону — Малюська
Політика
17 липня 2022
Кілька проросійських партій, чию діяльність в Україні заборонив суд, ...

У Болградському районі пограбували офіціантку
Одеська область
17 липня 2022
У Болградському районі пограбували офіціантку
У Болградській громаді Одеської області чоловік викрав мобільний телефон у офіці...
Небезпечний "ТІРАМІСУ": в Одесі збільшилась кількість хворих на сальмонельоз
Одеська область
17 липня 2022
Станом на 15 липня в Одесі зареєстровано 31 хворого на сальмонельоз, у тому числі 7 діте...
Видання «Кут огляду» зарєстроване 5 березня 2017 року. Сайт «Кут огляду» почав працювати з грудня 2018 року, до того часу «Кут огляду» працював виключно як друковане ЗМІ.
Авторські та суміжні права захищені.
Хто на сайті
На сайті 242 гостя та 0 користувачів
Популярні статті
Создание сайта интернет газеты "Сайтостроитель" создание сайта визитки







